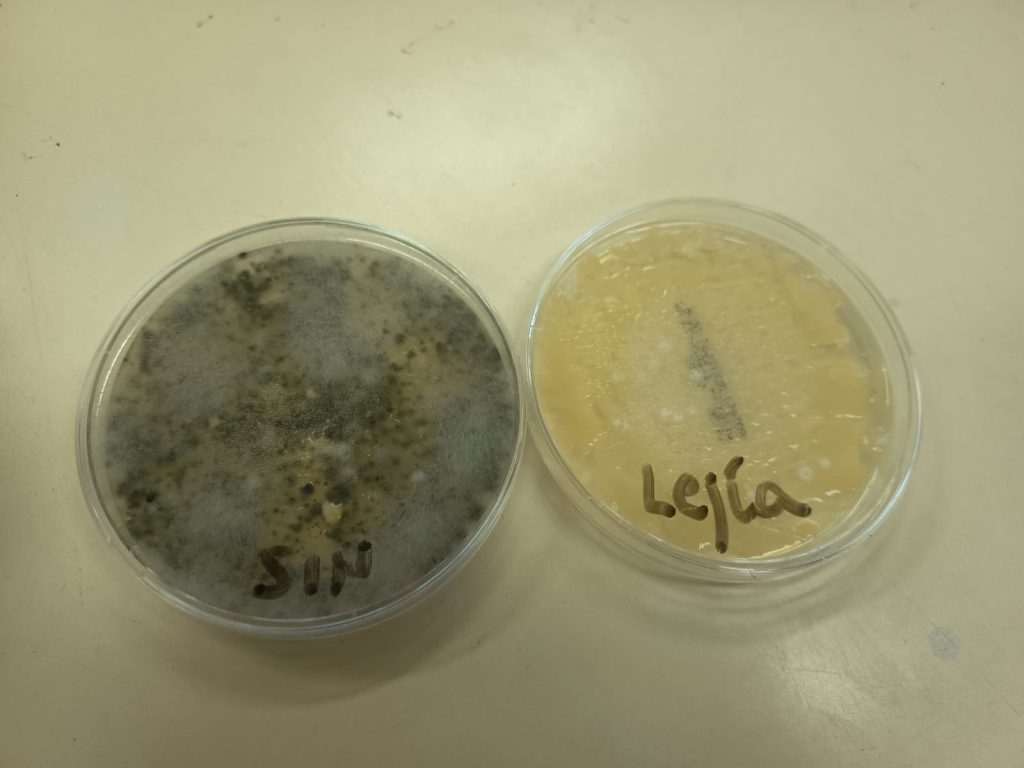

L’alumnat del cicle formatiu del CFGM de Sistemes Microinformàtics i Xarxes dins del mòdul Muntatge i Manteniment de Sistemes Informàtics del nostre centre està començant el resultat d’aprenentatge “Acobla un equip microinformàtic, interpretant plans i instruccions del fabricant aplicant tècniques de muntatge. “.
Estan realitzant el muntatge d’un ordinador (component a component), tenint en compte les recomanacions dels fabricants i sobretot mantenint les normes de seguretat al treball. Cal continuar fent aquestes activitats amb diferents models d’ordinadors, així aconseguim que el nostre alumnat obtinga les competències necessàries per a incorporar-se al món laboral.
Aquesta experiència també els permet guanyar confiança en les seues capacitats i preparar-se per a futurs desafiaments en el camp de la informàtica.